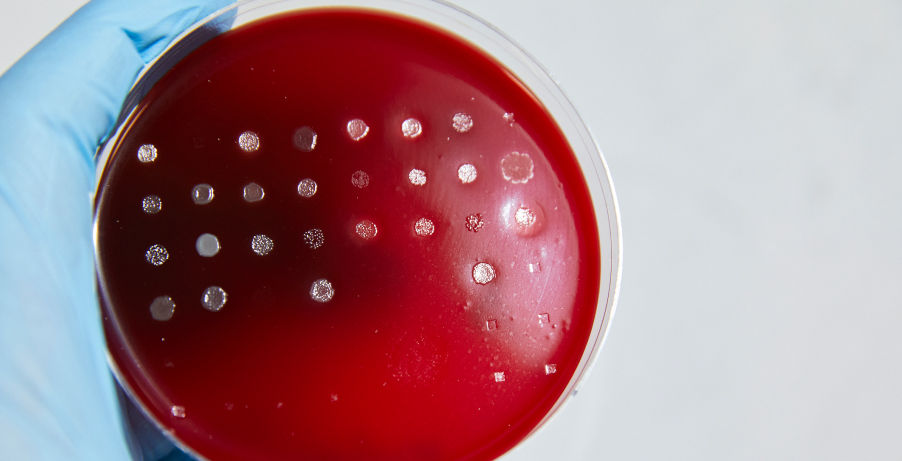
Close up of gloved hand holding red agar plate showing growth performance testing results for various bacterial strains

INTRODUCTION
Quality you can count on
Our standard process includes 20 quality control assays that we perform on our raw materials
and finished products. We maintain retention samples for the lifespan of each product so we can test its integrity
at any time, and we can also perform custom stability testing for your unique storage conditions.
- Raw Materials
- Agar Plates
- Microbial Culture Media
- Buffers and Reagents
- Water
We go beyond industry testing standards to ensure we are working with high-quality raw materials that will meet your requirements. We can also help source and test specialized raw materials, and customize testing for your products to help you meet specific requirements. Learn more.
We have refined our agar products and testing to make sure you get optimal performance and shelf life when they get to your lab. Incoming raw materials are screened for growth performance before being implemented on the floor, and final formulations are tested for consistency so you get reliable results from the first plate to the last in every batch.
With our ISO 13485:2016 certified facilities, we can help make sure your products meet your regulatory requirements from RUO to GMP. Our rigorous quality control and functional performance testing ensures batch-to-batch consistency, and in some cases, we can also perform custom quality testing using your choice of microorganism.
We offer an extensive suite of fully customizable quality control testing for our buffers and reagents. Standard assays for RUO buffers and reagents include pH, conductivity, osmolality, density, and top spread sterility. To meet the requirements for your finished good specifications, we can also perform custom assays including endotoxin, DNase, RNase, protease, PCR, microbial enumeration, and compendial sterility testing.
The performance and consistency of our products start with the quality of our water system, which is why we use the same water we sell to our customers in our own manufacturing.